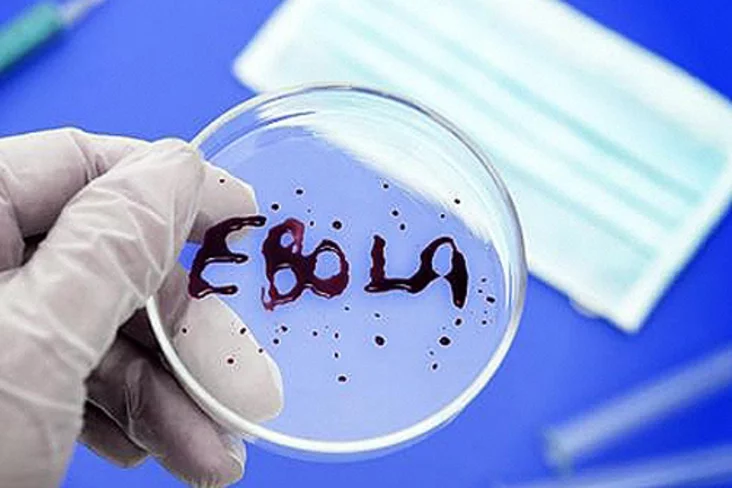

Сусветная арганізацыя аховы здароўя абвясціла пра тое, што эпідэмія ліхаманкі Эбола ў Ліберыі і ўсёй Заходняй Афрыцы завяршылася.
СААЗ заявіла пра заканчэнне перыяду актыўнай перадачы віруса — у Ліберыі не было зарэгістравана ніводнага новага выпадку вось ужо 42 дні.
Раней у мінулым годзе статус свабоднай ад Эболы краіны атрымалі Гвінея і Сьера-Леонэ.
У той жа час генеральны сакратар ААН Пан Гі Мун папярэдзіў, што Заходняя Афрыка ўсё яшчэ можа сутыкнуцца з абвастрэннем захворвання ў будучыні.
У выніку самай маштабнай у гісторыі ўспышкі ліхаманкі Эбола з снежні 2013 года памерлі больш за 11 тысяч чалавек.
Каментары